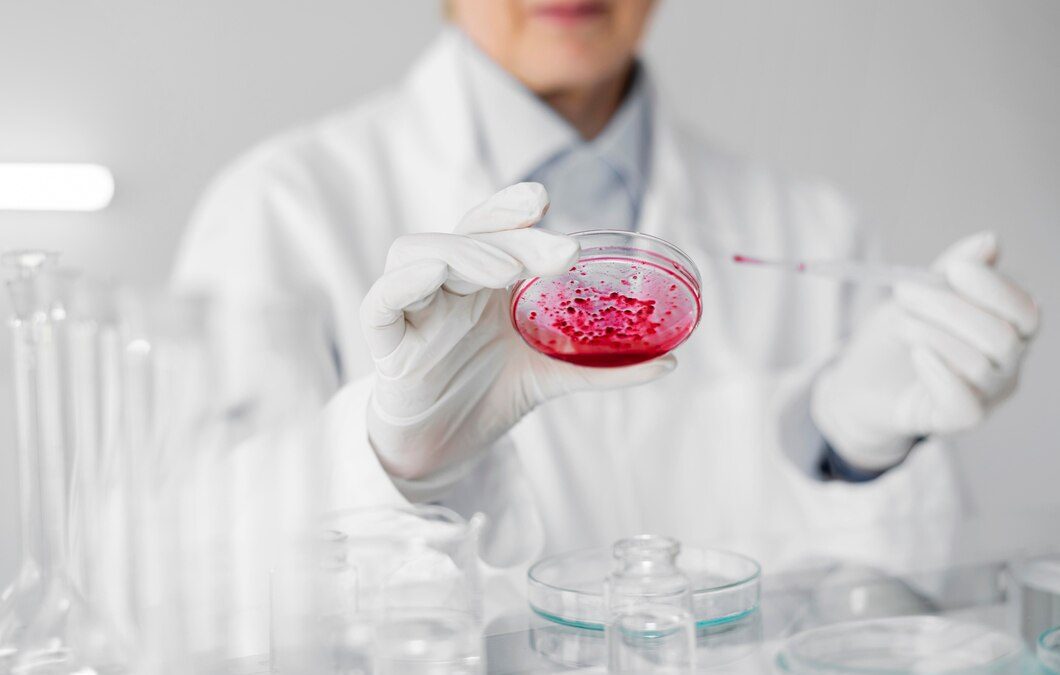

Are stem cell injections covered by insurance? This is a question that many patients in Miami ask when considering this innovative treatment. Stem cell therapy has shown promise in treating a range of conditions, from joint pain to chronic diseases, but understanding the intricacies of insurance coverage for medical procedures in Miami is essential before moving forward. At Miamitem Cell, we want to provide clear guidance to help you navigate the complexities of insurance coverage and make informed decisions about your own healthcare.
Factors Influencing Insurance Coverage For Stem Cell Injections
Determining whether stem cell injections are covered by insurance involves understanding several factors. Insurance companies evaluate treatments based on their classification, medical necessity, and policy details. Here’s a closer look at what influences coverage:
Classification of Treatment
Insurance companies often categorize Stem Cell Therapy Miami as experimental, which can impact whether stem cell injections are covered by insurance. However, as more research supports the effectiveness of stem cell therapy, some insurers are starting to cover these treatments under specific conditions.
Medical Necessity
Whether stem cell injections are covered by insurance can also depend on whether the treatment is deemed medically necessary. For instance, if Stem Cell Therapy Miami is recommended to treat a chronic condition like arthritis after other treatments have failed, your insurance may consider covering it. Discussing your specific medical situation with your healthcare provider is crucial to understanding how insurance might view your treatment.
Policy And Provider Variations
The question of Are stem cell injections covered by insurance often depends on specific policy and provider. Insurance coverage for medical procedures Miami can vary widely, with some policies offering partial coverage for Stem Cell Therapy Miami while others may deny it entirely. Reviewing your policy and consulting with your insurance provider will give you clearer picture of what is covered.
Common Scenarios Where Coverage May Or May Not Apply
When considering Stem Cell Therapy Miami, it’s important to understand the scenarios where insurance coverage for medical procedures Miami might be applicable. While every insurance plan is different, certain situations are more likely to be covered than others.
Covered Situations
- Post-Surgical Recovery: Some insurance companies may cover stem cell injections as part of a post-surgical recovery plan.
- Chronic Conditions: Stem Cell Therapy, Miami may be covered for chronic conditions such as arthritis or degenerative diseases, particularly if other treatments have proven ineffective.
- Clinical Trials: Participating in clinical trials often includes insurance coverage for medical procedures Miami, including stem cell injections as part of the study.
Non-Covered Situations
- Elective Procedures: Insurance is less likely to cover Stem Cell Therapy Miami when it is used for elective or cosmetic purposes.
- Experimental Status: Obtaining coverage may be difficult if your stem cell injections are considered experimental.
- Out-of-Network Providers: Using an out-of-network provider for Stem Cell Therapy Miami may result in partial or no coverage, depending on your insurance plan.
Tips For Discussing Stem Cell Injections With Your Insurance Provider
When asking, Are stem cell injections covered by insurance, it’s important to approach your insurance provider with the right questions and documentation. Here are some tips to help you navigate this conversation effectively:
- Request Detailed Information: Start by asking your insurance provider for specific details about insurance coverage for medical procedures Miami, particularly for Stem Cell Therapy Miami.
- Provide Medical Documentation: Having your healthcare provider submit detailed documentation can strengthen your case. This includes why stem cell injections are recommended and how they fit into your overall treatment plan.
- Inquire About Appeals: If coverage is denied, ask about the appeals process. Providing additional medical evidence may help overturn the decision.
- Explore Financing Options: If stem cell injections are not covered by insurance, consider discussing financing options with your provider. Many clinics in Miami offer payment plans to make Stem Cell Therapy Miami more accessible.
Conclusion
The question “Are Stem Cell Injections Covered by Insurance in Miami?” involves navigating a potentially complex issue, as determining insurance coverage can be challenging. However, being well-informed can empower you to make a more confident and informed decision about your treatment options and associated financial considerations. We’re committed to helping you understand your options for insurance coverage for medical procedures Miami. Whether you’re exploring Stem Cell Therapy Miami or need assistance navigating insurance, we’re here to support you every step of the way.
Contact us today to schedule a consultation and discuss your treatment options and insurance coverage in detail.